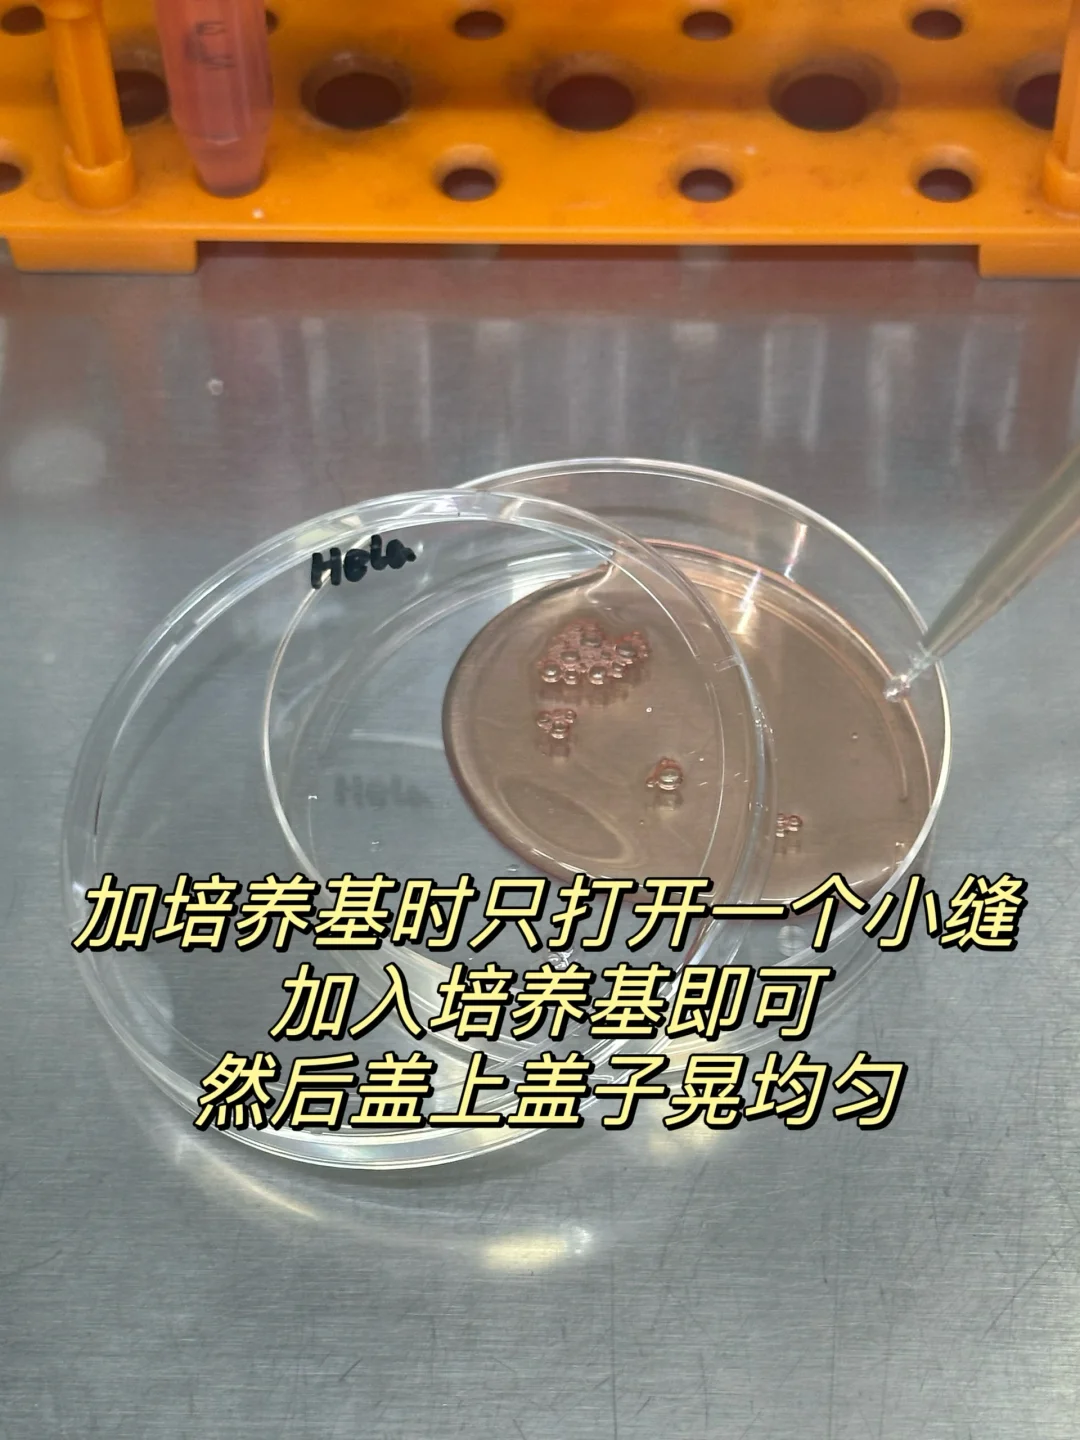
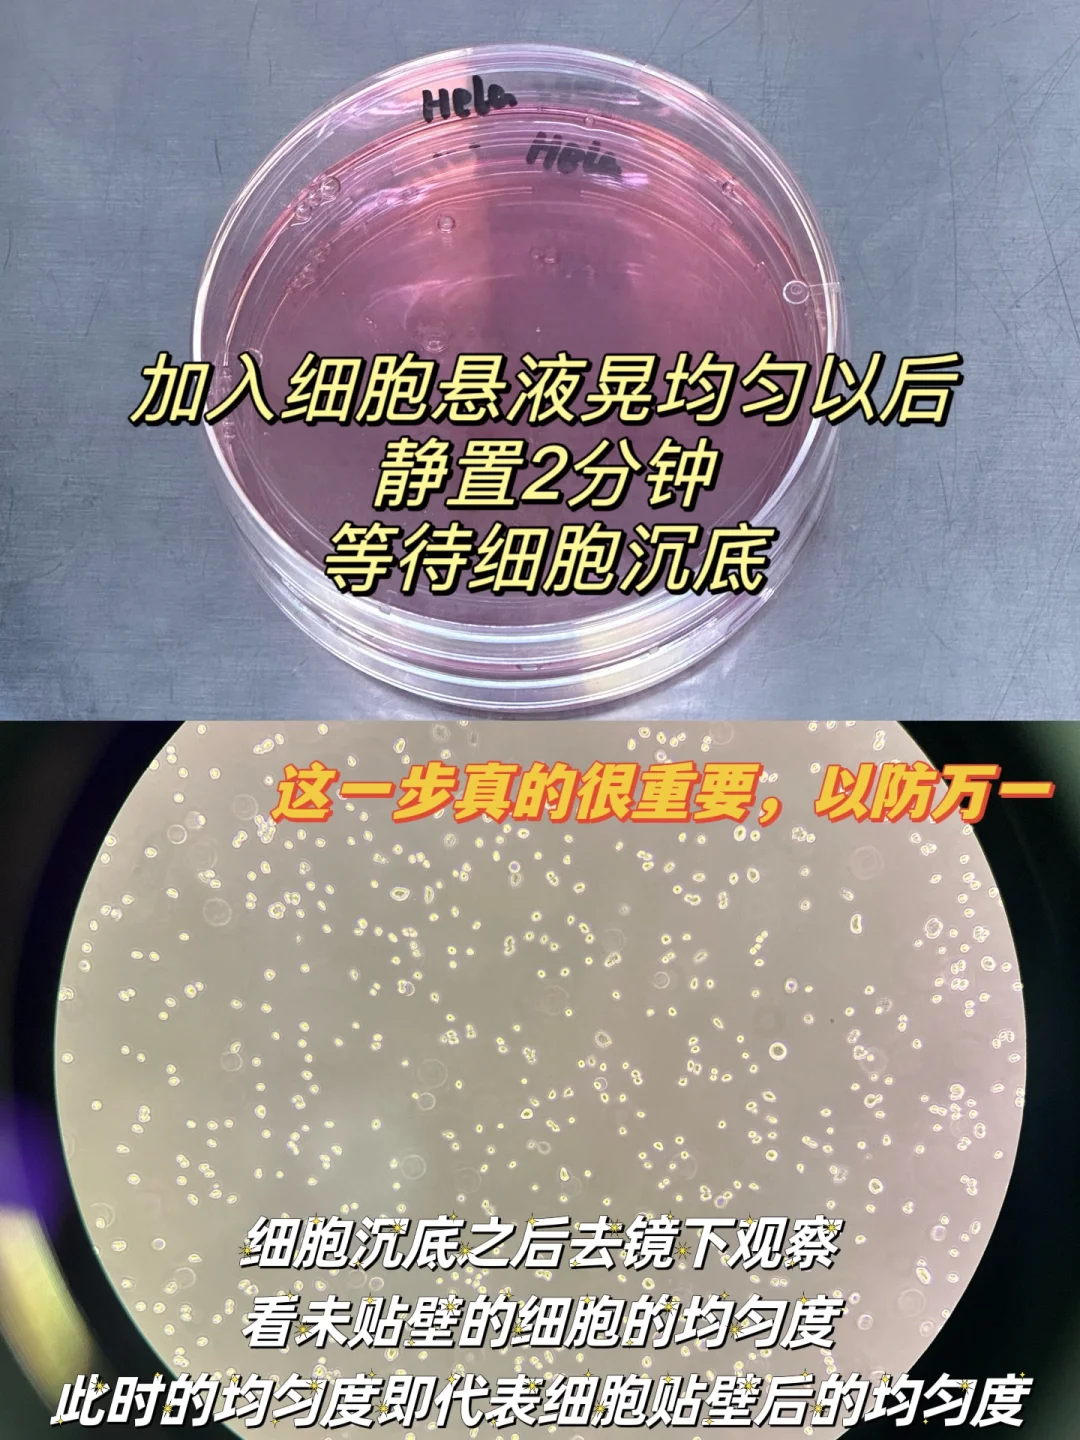

老有宝子问我细胞铺不匀是怎么回事,今天给大家分享一下我是如何搞定贴壁细胞的。
✅1.细胞离心之后用少量培养基重悬(3~5ml左右),吹打,吹打10~20次,把因离心紧挨在一块的细胞都吹开,吹成一粒一粒的。
✅2.细胞重悬液加入培养皿后晃匀,采用8字晃匀法。(图3实况图)
✅3.重点:晃匀之后检查有无气泡🫧,如果有气泡赶紧弄掉,戳破。
(图4展示了有气泡镜下细胞的样子,虽然在培养箱里气泡会自己消失,但是因气泡而不均匀的细胞就会一直那样子)
(把细胞悬液加入培养皿时就尽量不要把因吹打细胞悬液而产生的气泡打进去,可以弃掉。)
✅4.重点:晃匀之后静置2分钟!!!!(图5)静待细胞沉底,细胞沉底之后去显微镜下观察,此时的细胞未贴壁只是沉底,此时的细胞均匀度大概率就是细胞贴壁之后的均匀度。
因此:沉底的细胞看着均匀,就可以放入培养箱,如果不均匀,重新摇晃。
🎃PS:分享给大家我日常处理细胞的习惯:
1.往培养皿里加培养基时,培养皿的盖子只打开一个小缝即可,不用全部打开。(图2)
2.教大家一个开培养皿盖,关培养皿盖的手法,吸培养基,加培养基都适用。(图6实况图)这样可以尽可能保证细胞不污染,培养皿开口不对着人,一只手就能控制培养皿盖的开关,很方便。